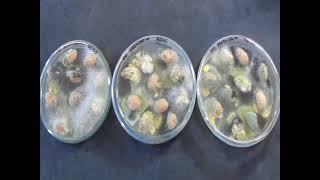
Plaqueamento direto para detecção de fungos (DIRECT PLATING)
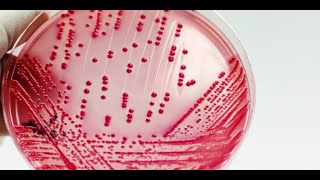
Técnicas de semeadura em microbiologia de alimentos

Microbiologia de Alimentos: Técnica de Plaqueamento Direto (Direct Plate)- Micologia. FUNGOS.
3.04k views1819 WordsCopy TextShare

Prof Marina Copetti
O foco das nossas aulas será nas técnicas, pois sabendo manejá-las, seguindo os protocolos recomenda...
Video Transcript:
o olá eu sou a marina professora do departamento de tecnologia e ciência de alimentos da universidade federal de santa maria e hoje apresentarei para vocês a técnica de plaqueamento direto essa técnica de plaqueamento direto é uma técnica que é rotineiramente usada para detecção de bolores em amostras particular das de alimentos é uma técnica extremamente simples a tratar o nós necessitaremos de placas contendo o meio de cultura que será utilizado nesse caso o nosso é o decorar literal dezoito por cento que é recomendado para alimentos de baixa atividade de água se for um alimento com alta
atividade de água ou seja uma atividade de água acima de zero 94 nós recomendamos o uso de meios chamado de flor rosa de bengala com cloranfenicol e e você deve estar acostumado se trabalha com rotina de laboratório a escutar muito a fungos devemos utilizar o ar das batata acidificado ou agar batata com cloranfenicol esse meio não é o meio recomendado para a maior parte das análises microbiológicas de alimentos visto que ele tem uma baixa é o mesmo nutricionalmente pobre tem uma baixa concentração de nutrientes ele é basicamente um extrato de batata e glicose o iago
é para solidificar então a gente fez prefere a comissão internacional de ginecologia de alimentos recomenda esses dois meses de cultura visto que eles foram desenhados especificamente para detecção de valores e leveduras em alimentos eles vão conter os nutrientes necessários requisitados por esses microrganismos e além de conter um antibiótico e um controlador de velocidade que é esse decorar então nós vamos fazer um médico altura conforme as instruções por causa nós já temos ele e pronto aqui mas é simplesmente seguir as instruções do fabricante esterilizar em autoclave e depois distribuir em placas de petri externa estéreis para
então fazermos a análise e e além do meio de cultura solidificado sério nós utilizaremos aniversário temos um béquer não é necessário que esteja externo um bastão de vidro para trabalhar com as amostras além de uma solução para desinfecção superficial que é o hipoclorito de sódio a 04 por cento o nosso trabalhamos hoje com duas amostras a amêndoa ii o e pipoca são duas amostras que tradicionalmente pode estar contaminados com fungos toxigênicos e também com o único toxinas além disso será necessário uma pinça para retirarmos a amostra então veja não é necessário um pipetador ponteira também
não é necessário tubos parte dos sonhos visto que nós apenas desinfetar emos a superfície dessas dessas amostras e lá cearemos elas direto no bic o número de amostras a ser analisado vai depender da contaminação ou da frequência de ocorrência desse fungo no alimento normalmente a gente trabalha com a morte com clareamento de 10 grãos por placas máquinas faremos duplicado o que é um total de vinte grãos laqueados em cada placa se for com a mostra grande com uma nós eu posso necessitar de placas maiores ou então que eu coloque um número menor de de amostras
vegetais e celulares dentro de cada placa de petri há 18 simplesmente depois que eu fizesse está desinfecção por um minuto se é uma mostra um tem uma contaminação superficial do ambiente muito alta eu devo usar dois minutos é importante também respeitar a quantidade visto que o hipoclorito de sódio inativado em matéria orgânica que eu coloque uma por exemplo as amostras estavam almoçando da do pote que eu coloco mais ou menos metade do pote para fazer uma uma desinfecção adequada algo que é importante também é a destreza com as com a placa de pé às vezes
as pessoas ai meu deus como ela consegue segurar uma placa de petri trabalhar com bico de dulce sem o que o correspondente e é importante que você tem a mão e posicione a placa sobre os três dedos deixando livre polegar e indicador então vejam que ela está totalmente suspensa eu vou prender lá com o polegar e dica agora e abrisse tão importante quer saber tura maior seja feita em direção a a chama do nosso do nosso bico de busen e com a chama entre o analista e amostra eu vou demonstrar com a mão esquerda para
que com a mão direita desculpa para que vocês vejam melhores melhor mas pessoas destra deve utilizar preferencialmente a mão esquerda e pessoas carinhosas deve suspender na mão direita direita é porque se eu soubesse eu vou segurar com a mão esquerda que teoricamente é a menos a porque eu vou precisar da outra mão para pegar a minha mostra então eu destra mão esquerda solta placa contendo meio de cultura histérico aqui vocês vejam que eu não estou com bico de você ligado só estou demonstrando sol tu abre pego a minha mostra já já desinfetada e posicionando na
placa e é recomendado que vocês façam o posicionamento dela pelas extremidades ou quadrante então a primeira seria as 12 horas segunda 6 horas terceira 39 depois na metade dessa então ele vai ficar um grão 1 2 3 4 5 6 7 8 e centrais e assim acabou de ser o nossa nossa nossa com acabamento as amostras serão conduzidos ao a estufa de incubação e é muito importante que vocês manuseie com cuidado porque depois que vocês colocarem os grãos e se vocês por descuido interferem a placa ou inclinar em a mesma esses grãos podem se mover
e isso é indesejável porque poderá já ter liberado esporos no placa e isso vai interferir com o resultado da análise eu jamais devo pegar esses grãos e reposicionar os na placa eu posso se isso acontecer e tenho que reiniciar uma análise será que é apresentado um esquema de plaqueamento direto essa técnica é usada rotineiramente para várias vezes de valores em alimentos particulares seja geramos ou amostras como e aí em termos de uma amostra particular por exemplo o verão de amendoim uma solução de hipoclorito de sódio a 04 por cento que deve ser preparada na festa
cidade parar de fumar chamado perda da esse cara e pode que ele pode utilizar e adicionamos estamos azuis e pensamos essa mostra durante um minuto utilizando com auxílio de um bastão de vidro posteriormente o líquido e aí a pesquisa serão descarregadas e esses grãos serão dispostos em portas de fede contendo um médico cultura de escolhido preferencialmente pelos quadrantes então uma mostra será largada aqui com auxílio de uma e aí tô conseguindo e lembre-se exposição simplesmente a ser levada por 25 graus durante 5 a 7 dias e assim será usado e aí e é uma bastante
rápida e simples de ser realizada o olá eu sou a jéssica só mestranda do programa de pós-graduação em tecnologia de alimentos universidade federal de santa maria e hoje deu uma estarei a técnica departamento direto né mas vamos fazer a técnica usando duas amostras o amendoim e o milho tava fazendo aplicada casa amostra professora maria já explicou que tinha juíza 10 grãos em cada placa então ou seja nós vamos precisar de 20 graus mas como vocês podem ver tem mais de 20 graus na nosso mac por quê porque você correu um acidente você tem reservas tem
alimentos reserva para colocar as placas bom então vamos começar com amendoim sempre coloca o volume de hipoclorito de sódio superior ao volume 2° ele porque o cloro é rapidamente desnatado pela matéria orgânica então chegou falando muito as pernas cama e após um minuto você tirar oi oi para o código é melhor aquela pancada já foi previamente higienizada assim como as minhas mãos e aí bom retiro máximo que puder agora se aplicasse claro coloco o nome da técnica laqueamento direto meu nome ea data de hoje fora flambo a minha pinça que é com ela que eu
vou retirar os grãos do béquer e vou colocar e lá na placa eu deixa esfriar um pouco pois assim você colocar ela tão quente como tá agora eu posso matar eliminar os microorganismos presentes na amostra bom então a gente abre a placa conforme nos ensinou o bom e coloca e aí u2 o preço 14 15 e aí 16 o frete é a coisa [Música] 19 e aí e é importante na hora de colocar na bancada tomar cuidado pois nos podem rolar colocar uma segunda claro não seja tão barato pinça pois é a mesma mostra nós
somos os integrantes planta e aí e agora faremos como convite pipoca e aí e aí e aí e aí então perto do bastante fantasma um minuto retirar e é para mim e aí a placa e identificar pagamento direto meu nome ea data de hoje quando a pizza e aí e deixamos agora rastrear e sempre perto da shampoo que ao redor da chama tem 10 centímetros esterilidade e aí e aí e aí [Música] g1 a dor 13 e aí aí sim hein é sim 17 e aí oi oi oi a nossa é há 10 horas e
aí e agora nós vamos a passar fita crepe e aí e aí e como muito cuidado nocaus gramas e e aí e aí e aí e aí e colocar o nome da técnica oi meu nome e a data da leitura daqui a sete dias e aí e aí e aí e aí e aí e aí e aí e aí e aí e aí e as placas serão armazenados na esposa que está a 25 graus celsius e ficaram por sete dias e e depois de uma semana nós retornamos com a leitura dos resultados das nossas análises
essa aqui são as placas referentes ao relacionamento directo que é uma técnica comumente utilizada para fungos como nós destacamos no início da aula e nós tivemos resultados extremos e é uma nossas amostras de pipoca não teve nenhum crescimento fúngico ou seja zero por cento de infecção e as nossas amostras de amendoim no contrário houve sem por cento de infecção e com seja todos os grãos de amendoim plaqueados eles estavam contaminados internamente por fungos visto que nós fizemos uma desinfecção superficial e claro nesse essa técnica nesse momento é só para contagem mas já podemos destacar que
a fungos toxigênicos embora a maior parte dos fungos presentes nessa mostra seja um fungos xerofilicos que crescem alimentos de baixa atividade de água nós temos um aspergillus cês tão suave provavelmente deve ser o aspergillus flavus que é um potencial produtor se a sua toxina arc x12 em duas amostras nessa placa o ou seja isso corresponde aos vinte por cento de infecção nessa outra placa é esse funk é uma mais relevante ele está em uma duas três se você já trinta por cento uma média de infecção e 25 por cento então essa é a nossa leitura
e com isso nós concluímos essa aula prática dúvidas comentários envie um e-mail ou deixe um comentário no vídeo
Related Videos

25:17
Microbiologia de Alimentos: Técnica de Pla...
Prof Marina Copetti
17,687 views

15:04
Bioprocessing Part 1: Fermentation
BioNetwork
863,709 views

1:11:53
Aula 04- Os 5 passos para dominar a área d...
Canal Cranium
549 views
6:52
Plaqueamento direto para detecção de fungo...
Prof Marina Copetti
1,440 views

58:07
Real-Time PCR in Action
USDA Animal and Plant Health Inspection Service
465,079 views

45:08
Aula Pratica 1 - Material e técnicas util...
Caio Rachid
18,339 views

26:18
Microbiologia de Alimentos: Técnica de Pla...
Prof Marina Copetti
8,751 views
50:33
Técnicas de semeadura em microbiologia de ...
Elisângela Serenato Madalozzo
873 views

38:38
Microbiologia de Alimentos: Técnica do Núm...
Prof Marina Copetti
16,280 views

49:39
REINO FUNGI - FUNGOS - Aula Completa | Bio...
Biologia com Samuel Cunha
1,120,385 views

31:50
Microbiologia Médica: Antibiograma
CS Ciências da Saúde
23,529 views

14:37
Sanger DNA Sequencing, From Then to Now.
ClevaLab
81,232 views

15:09
ANÁLISE MICROBIOLÓGICA DA ÁGUA (NMP) - PRO...
Alexandre Funck
32,487 views

29:37
RDC nº331 e IN nº60 (1/2): padrões microbi...
Fabíola Dorneles
9,920 views

37:26
Molecular animation – Tech Talk by Drew Be...
WEHImovies
85,129 views

24:02
DOENÇAS CAUSADAS POR FUNGOS - Micoses | Bi...
Biologia com Samuel Cunha
119,760 views

28:52
Métodos Analíticos de Microbiologia de Ali...
Cris Zaicovski
38,885 views

12:40
Estrutura e Classificação dos Fungos - Mic...
Mundo Microbiologia
23,275 views

51:35
Contagem de coliformes totais, termotolera...
Elisângela Serenato Madalozzo
8,249 views

19:18
Videoaula 3 - Coloração de Gram e Visualiz...
Fernando Freitas
7,532 views